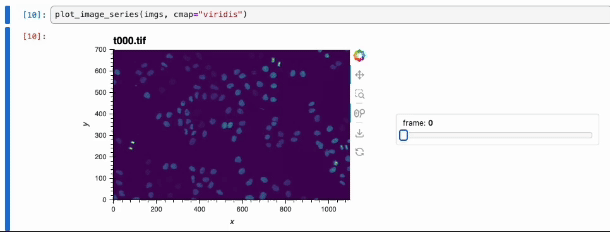

Neumann, B., et al. (2010). Phenotypic profiling of the human genome by time-lapse microscpy reveals cell division genes. Nature, 464, 721-727.After loading in our image series as a Mantle
image_directory data entity, we read in the images using scikit-image. Then, we construct a Holoviews HoloMap of Holoviews Image plots that display our images.